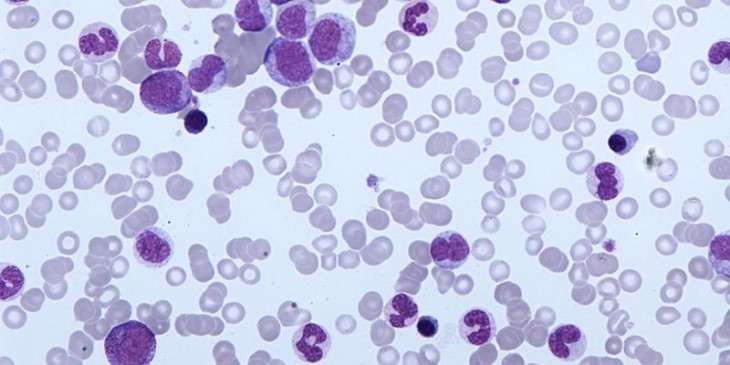

All posts tagged Hallan una nueva diana molecular para combatir cánceres agresivos
-
Hallan una nueva diana molecular para combatir cánceres agresivos
10/02/2014 · No comments
Colima, Col., 10 de febrero 2014 (Colima Medios) El análisis de los genomas de dos hermanas…
Avisos
Columnistas
Cartelera:
Toma Conciencia
Tiempo
Síguenos
Memes
Finanzas















